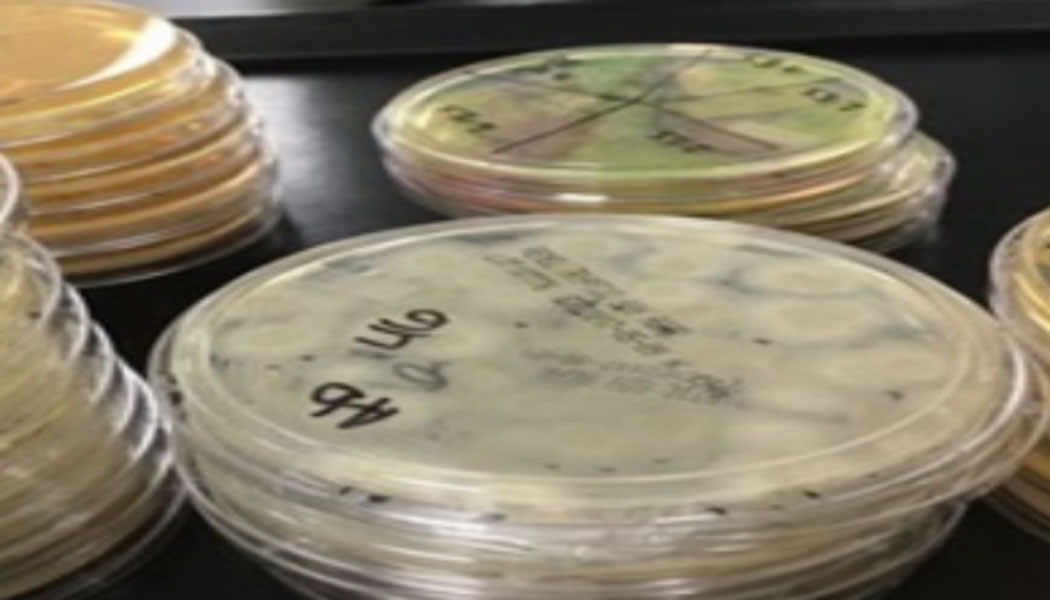
非無菌藥品微生物限度

?驗證/服務
做專業的環境微生物控制整體解決方案供應商
產品分類
過氧化氫環境滅菌
無菌檢測(醫療器械和藥品)
非無菌藥品微生物限度
隔離器除菌循環開發及驗證
醫療器械初始污染菌
潔凈室及相關受控環境監測
濾膜細菌挑戰試驗
抑菌劑效力檢測
消毒劑備案檢測
制藥環境消毒劑殺滅效能檢測
生物指示劑抗力

選擇區號